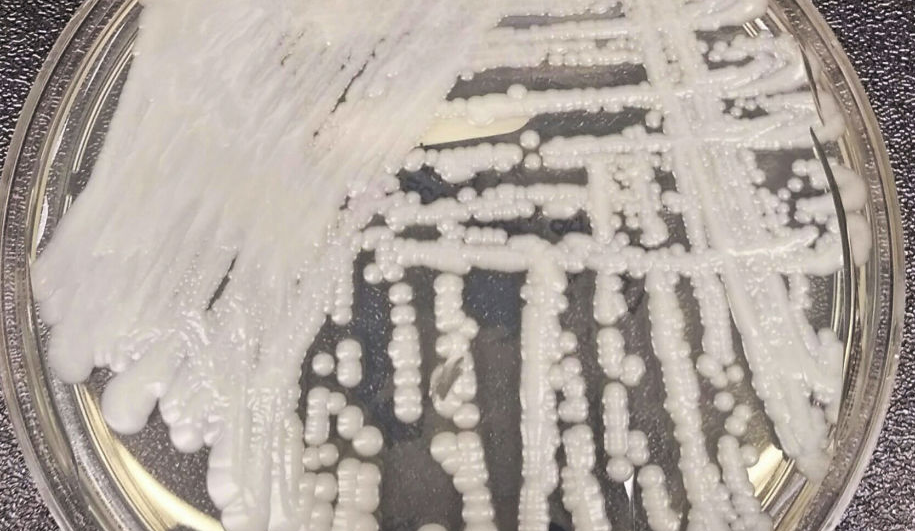

乌克兰研究所危险病毒毒株失窃 官方介入调查
文章分类:中国新闻 发布时间:2021-06-14  ACTV 阅读( 0 )
ACTV 阅读( 0 )
俄媒资料图
海外网6月11日电 乌克兰一女子涉嫌盗走保存在该国国家微生物毒株中心的禽鸟类纽卡斯尔病毒毒株,目前正被调查,或面临5年监禁。
据俄罗斯卫星通讯社报道,乌克兰总检察长办公室网站上消息称,涉事女子为乌克兰国家生物技术和微生物毒株科学控制研究所前工作人员,她涉嫌侵占危险病毒毒株,这些毒株被定义为动物传染病的病原体,可无国界地大规模快速传播。对此,乌克兰调查人员已介入调查。
调查资料显示,这名女子把偷来的病毒样本藏在自家冰箱内,并计划出售它们。目前调查人员已将没收在其冰箱里找到的瓶子。
根据乌克兰法律规定,嫌疑人可能面临5年监禁。(海外网 姚凯红)
海外网版权作品,未经授权不得转载。
 澳大利亚澳华电视传媒 AUS-CHINA TV MEDIA
澳大利亚澳华电视传媒 AUS-CHINA TV MEDIA






